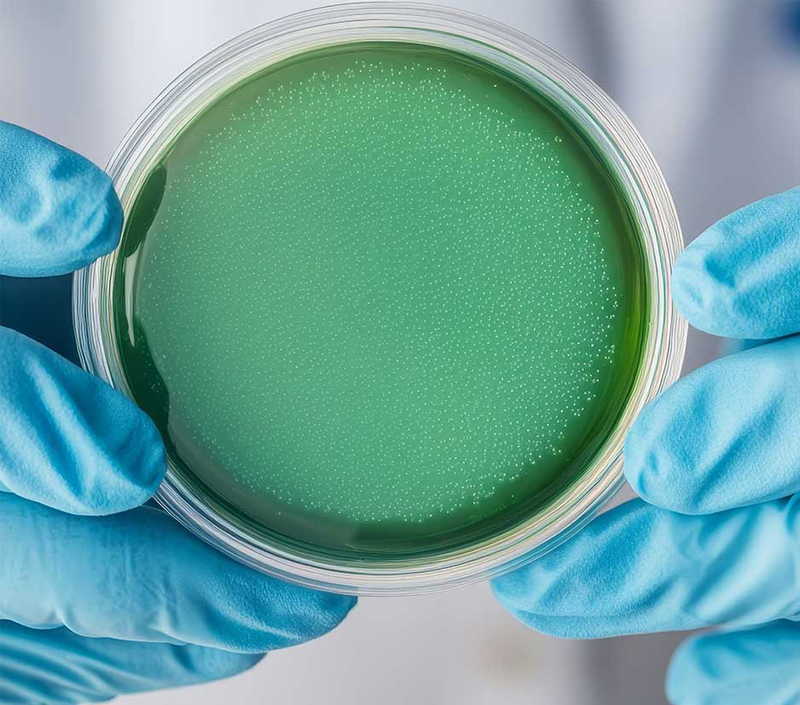
Balances Gut Microbiota and Digestive Health

- Liposomal Vitamin C
- Liposomal Vitamin D3
- Liposomal Vitamin E
- Liposomal Vitamin K2
- Liposomal Vitamin B2
- Liposomal Vitamin B Complex
- Liposomal Folic Acid
- Liposomal Alpha Lipoic Acid
- Liposomal Glutathione
- Liposomal Quercetin
- Liposomal Coenzyme Q10
- Liposomal Curcumin
- Liposomal Resveratrol
- Liposomal Silymarin
- Liposomal Ashwagandha
- Liposomal Hyaluronic Acid
- Liposomal Melatonin
- Liposomal Collagen Type II
 EN
EN
 jp
jp  ko
ko  fr
fr  de
de  es
es  ru
ru  pt
pt  ar
ar  pl
pl  vi
vi